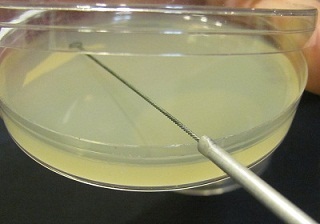
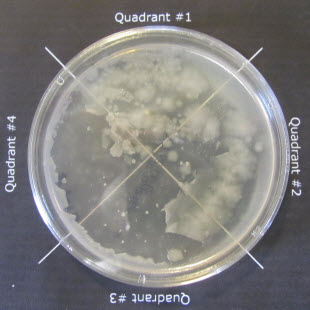

1/60
Looks like no tags are added yet.
Name | Mastery | Learn | Test | Matching | Spaced | Call with Kai |
|---|
No analytics yet
Send a link to your students to track their progress
Petri dishes using a variety of agar media are an excellent device for the aerobic cultivation of microbes such as bacteria and fungi. How are they placed into an incubator for growth?
Upside Down
Why is a plate containing an agar medium especially useful to grow bacterial cultures?
Agar containing media provide a solid surface for colony growth
A colony is:
a visible mass of microbial cells, is derived from a single cell, can be described by its morphological characteristics
True or false: It is incorrect to describe colonies by their size, color or texture
false
You observe a sample of pond water under the microscope. The ocular lens is 10X. If you look at the specimen at 400X magnification, which objective lens are you using?
40X
What is the function of the oil used to view samples with the oil immersion lens?
Oil prevents the scattering of light rays and increases the resolution
What is the purpose of staining samples to be viewed with a light microscope?
Stains increase contrast, can present differentiation of major categories of microbes based on the color reaction of cells, Staining makes inconspicuous features stand out, Positively charged stain is attracted to negatively charged cell walls and stick to the cell and giving it color
True or false: Differential stains use complex staining techniques and require two differently colored stains to clearly contrast cell types or cell parts
True
The Nigrosin solution is:
A simple negative stain
The gram stain is:
A differential stain
Agar plates should be incubates:
Agar side up
In our plate-streaking lab exercise we used a liquid or slant bacterial culture to:
Inoculate the plate
When streaking a plate, the inoculating loop should be flamed or incinerated:
before placing the loop in the culture to be streaked, at the end of streaking, between each zone
To clean our work surface both before and after performing out lab exercises we use what solution?
5-10% bleach
Oh no! You observe that the plates you streaked have a “lawn” of bacteria instead of the discrete colonies you expected. What is (are) the likely cause(s) of this?
The plates were incubated right side up, The appropriate streaking technique was not used
Ture or false: You observe that your bacterial plate has contamination. This is most likely due to poor aseptic technique
True
True or false: Petri dishes containing bacterial or fungal cultures should be placed into the appropriate biohazard waste bags at the end of the lab
True
True or false: An emergency alarm sounds while you are in lab. Unless you are told to shelter in place, you should leave the lab and using the closest exit stairs evacuate to location at least 300 feet from the building. You should stay with the class so that your instructor can take roll, and remain outside the building until the all clear is given
True
You accidentally splash a bacterial culture into your eyes. You should first:
Immediately go to the eyewash station and rinse your eyes with copious amounts of water
The purpose of streaking a plate from a bacterial culture is to obtain:
To isolate individual colonies that could be used for identification testing
Lab 1: Why is tryptic soy agar used in this experiment?
To isolate and cultivate a wide variety of microorganisms
Why are plates inverted prior to incubation?
To prevent spreading and smearing and prevent contamination
Why is the Petri dish so suitable for the aerobic cultivation of microorganisms?
Balances gas exchange, surface area, and protection since aerobic is oxygen-dependent
Why do you flame the necks of the tubes immediately after uncapping and before replacing caps?
To prevent contamination and growth of unwanted bacteria
How would you know if you contaminated the cultures during transfer?
If you can see different colonies of bacteria, cloudiness, or color change
What is the most likely explanation for no growth when growth is expected?
The inoculum was killed during transfer process or technique/seeding issues
What is the most likely explanation for growth when non is expected?
You don’t flame correctly causing contamination, failure of aseptic techniques, and failure to properly sterilize lab tools and resources
Why is this technique called a negative stain?
The dye used is negative, and the contrast changes to dark
A compound microscope uses two lenses at once to magnify the image of a specimen. The ____lens is found in the eyepiece and the ____lens is found in the revolving nosepiece:
Ocular; Objective
Which component of the microscope is found directly under the stage, and contains two sets of lenses that collect and concentrate light as it passes upward from the light as it passes upward from the light source into the lens systems?:
Abbe Condenser
Which property of the lens describes its ability to show two adjacent objects as discrete entities?:
Resolving Power
Loss of bent, or refracted, light results in a reduced numerical aperture, which diminishes the resolving power of the objective lens. Adding which of the following substances between the slide and the lens acts to decrease the refraction of light?
Oil
Which of the following objective lenses is the ONLY lens that should be used with oil immersion?:
High-Power Lens (100X)
The use of clean lenses increases the efficiency of the microscope. While dry lenses should be cleaned with ___, the oil-immersion lens can be cleaned with ____, followed by 95% ethanol:
Lens paper; Xylem
Which of the following microscope parts should routinely be adjusted to control the light source and provide optimal illumination of the specimen?:
Iris Diaphragm
Which of the following observations would suggest that a plate was inoculated with pure (axenic) culture?:
Isolated colonies are all white in color and about the same size
Imagine that you forgot to flame the loop before streaking the inoculum from the first quadrant into the second quadrant. What is the most likely consequence of this error?
Too much bacterial growth outside the first quadrant
A student INCORRECTLY streaks the plate according to the diagram below, creating streaks in the order: a,b,c,d. Which of the following is a streaking error shown in the illustration?:

Which of the following images shows how to properly open a Petri plate to steak the agar?:
Where should you label your Petri plate with information about the culture?:
On the bottom of the plate
A student streaks a plate using inoculum from a broth culture tube. The culture tube was labeled “Escherichia coli”, indicating that the culture was composed of a single bacterial species. Which of the following best explains the unexpected plate result shown here after incubation?:
The culture in the tube was contaminated
If a correctly streaked plate were INCORRECTLY incubated right side up (instead of upside down), which of the following plate results would you most likely see?:
A student performs a streak plate using inoculum from a broth culture tube. The culture tube was labeled “Escherichia coli”, indicating that the culture was composed of a single bacterial species. Which of the following best explains this unexpected plate result seen after incubation?:
The plate was exposed to airborne contaminants
A student performs a streak plate using inoculum from a broth culture tube. The culture tube was labeled “Escherichia coli”, indicating that the culture was composed of a single bacterial species. Which of the following best explains this unexpected plate result seen after incubation?:
The loop wasn’t flamed between quadrant streaks
A streak plate was prepared from an unknown culture. Which of the following best explains this plate result seen after incubation?:
The unknown culture contains two species of bacteria
The isolation streak plate below failed to isolate individual colonies. What is the most likely reason that isolation was not obtained by this plate?
The loop did not obtain enough bacteria from quadrant I to move into quadrant II
Which of the following could explain why this isolation streak plate failed to produce individual colonies?
The loop was not flamed between quadrant inoculations, Fresh bacterial sample was added to each quadrant
What is an antibiotic?:
A chemical that inhibits microbial growth
What does the Kirby-Bauer test assess?:
The susceptibility of an organism to a set of antibiotics
What characteristic of the Kirby-Bauer test helps scientists to determine if a microorganism is susceptible to an antibiotic?:
The diameter of the zone of inhibition surrounding the antibiotic disks
What is a zone:?
The area around the antibiotic disk in which bacteria cannot grow
Why is it critical to use aseptic technique when transferring the antibiotic disks to the agar?:
Contaminating organisms could produce their own antibiotics - contaminating microorganisms could alter the diffusion of the antibiotics through the agar - contaminating microorganisms could break down the antibiotics
What are the three possible outcomes for each antibiotic: microorganism pair in a Kirby-Bauer assay?:
Susceptible, resistant, or intermediate
What is an inoculum?
The bacteria transferred to a new medium
Which of the following best describes aseptic technique?:
To manipulate bacteria without introducing contaminants
A student properly flames her loop but then forgets to let it cool. Instead, she immediately inserts the hot loop into her broth culture. What is the most important issue associated with this mistake?
The hot loop may create aerosols when it touches the culture
If a student forgets to flame the mouth of a broth culture tube before transferring culture to it, what might result?
the medium in the tube might become contaminated
A student inoculated an agar slant with inoculum from a colony on a Petri plate. The slant was incubated at an appropriate growth temperature for this species for 2 days. The results are shown in this photograph. Which hypothesis best explains why there is so little growth on the agar?
The loop dug into the agar during inoculation
You have finished sterilizing your inoculation loop using the Bunsen Burner, but realized you need to leave your bench to get the media you intend to inoculate. What should you do with your sterilized loop to prevent needing to sterilize it again?
Place the loop in a test tube rack, loop side up, to prevent the loop from touching a surface
When you inoculate a plate, what do you with the lid of the plate?
Holding the lid in your hand, partially cover the plate with lid during the inoculation